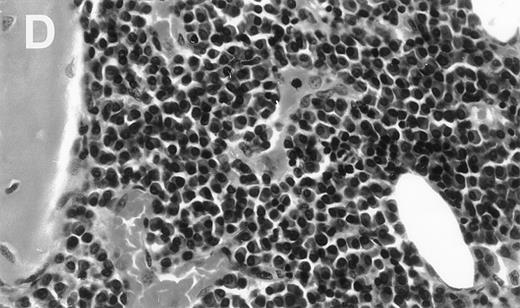
Fig. 3. Human Ig levels (A through C ) and histology of decalcified human bone sections ( D through F ) from SCID-hu hosts inoculated with bone marrow cells ( A and D ), purified plasma cells ( B and E ), and PC-depleted bone marrow cells ( C and F ) from patient no. 2. Inserts demonstrate CD38/CD45 fluorescent profiles and sort windows of cells used for each host.
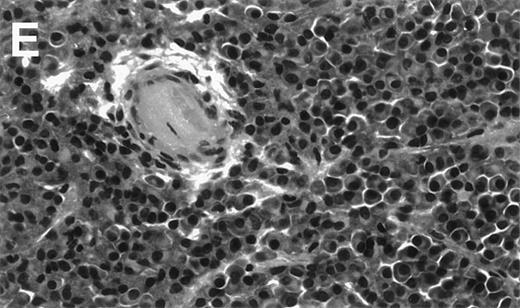
Fig. 3. Human Ig levels (A through C ) and histology of decalcified human bone sections ( D through F ) from SCID-hu hosts inoculated with bone marrow cells ( A and D ), purified plasma cells ( B and E ), and PC-depleted bone marrow cells ( C and F ) from patient no. 2. Inserts demonstrate CD38/CD45 fluorescent profiles and sort windows of cells used for each host.

The low proliferative activity of myeloma plasma cells prompted the notion that the clonotypic B cells that exist in the blood and bone marrow of all myeloma patients contain the proliferative myeloma cells (stem cell). We have exploited our severe combined immunodeficiency (SCID)-hu host system for primary myeloma to investigate whether myeloma plasma cells are capable of sustained proliferation. Purified CD38++CD45− plasma cells consistently grew and produced myeloma and its manifestations in SCID-hu hosts (8 of 9 experiments). In contrast, the plasma cell-depleted bone marrow cells from 6 patients did not grow or produce myeloma in SCID-hu hosts. Similarly, whereas plasma-cell containing blood cells from 4 patients grew and produced myeloma in hosts, neither the PC-depleted blood cells from 3 of the patients nor a blood specimen that did not contain plasma cells grew in SCID-hu hosts, regardless of their CD19-expressing cell contents. Also, in hosts injected with blood cells, although the myeloma cells were able to disseminate through the murine host system, they were only able to grow in the human bones within a human microenvironment and were not detectable in the murine blood or other organs. Interestingly, the circulating plasma cells appear to grow more avidly in the SCID-hu hosts than their bone marrow counterparts, suggesting that they represent a subpopulation of the plasma cells in the bone marrow. Although our studies clearly demonstrate the proliferative potential of myeloma plasma cells, they are suggestive, not conclusive, as to the existence of a preplasmacytic myeloma progenitor cell.
MULTIPLE MYELOMA is a B-cell neoplasia, characteristically associated with monoclonal tumor cells of plasma cells morphology and function. Disease manifestations include high levels of monoclonal Igs, severe skeletal anomalies resulting from activation of osteoclasts and bone resorption, and immune suppression. Myeloma tumor cells display low proliferative activity expressed in labeling indices of less than 0.5% in all but the most advanced stages of the disease. This low proliferative potential, expressed also in lack of in vitro growth and the inability to establish cell lines but from the most advanced cases of extramedullar myeloma, has prompted the notion that a cell earlier along the B-cell differentiation pathway is the proliferative progenitor of the myeloma plasma cell. Indeed, B lymphocytes and pre-B cells that carry the signature of the myeloma clone have been identified. Initially these cells were recognized by their idiotype,1,2 by their Ig isotype (light chain excess), and by their abnormal phenotype.3-7 More recently, the specific sequence of the third complementarity determining region of the rearranged myeloma Ig gene, CDR3, was used to identify clonal B lymphocytes and pre-B cells.8-13 Preplasmacytic cells in the blood and bone marrow of patients with myeloma could be differentiated into monotypic plasma cells.14-16 It was suggested by some that the circulating clonal B cells contain the myeloma stem cells, that they are resistant to therapy, and that they are responsible for disease dissemination14 and relapse.17 18 However, the debate on the role of clonal B and pre-B cells in the disease process could not be tested for lack of an adequate assay.
The SCID-hu host19 provides a hospitable host for primary human acute leukemia cells.20 Recently, we reported that the SCID-hu host reproducibly supports the growth of myeloma cells and development of typical myeloma manifestations when inoculated with freshly obtained bone marrow cells from patients with myeloma.21 We have used the SCID-hu host system to determine if purified myeloma plasma cells alone can grow and produce myeloma in SCID-hu hosts or if production of myeloma in the hosts requires preplasmacytic and accessory cells present in the bone marrow and blood.
MATERIALS AND METHODS
Myeloma cells.
Heparinized bone marrow aspirates and peripheral blood samples were obtained from patients with active myeloma during scheduled clinic visits. Signed institutional research board-approved consent forms were signed by all patients and are kept on record. Relevant patient information is provided in Table 1. The samples were separated using ficoll hypaque centrifugation (Histopaque; Pharmacia, Uppsala, Sweden). The proportion of myeloma cells in the light density cell preparations (specific gravity, ≤1.077 g/mL) was determined using CD38/CD45 flow cytometry.13,22 Myeloma plasma cells were identified by their CD38++CD45negative-positive fluorescence profile and their light scatter properties.13,22CD38++CD45− Plasma cells were purified to a high degree of purity using fluorescence-activated cell sorter. When indicated, a second set of sort windows was set, excluding all plasma cells (both CD38++CD45− and CD38++CD45+), and the nonplasmacytic cells were sorted and collected simultaneously; these constituted the plasma cell-depleted cells. Aliquots of the sorted cells were used to prepare slides for morphological and cIg analysis. When cell quantity allowed, purity was determined by repeat flow cytometry of ≥20,000 cells. Purity of the plasma cells was ≥99%, with an occasional neutrophil or eosinophil visible on morphological examination; the plasma cell-depleted specimens contained ≤1% cells that fell within the plasma cell window (Fig 1). The myeloma clone in each sample was characterized by CDRIII- and allele-specific oligomer (ASO)-polymerase chain reaction (PCR).13,23BudR labeling index of light chain restricted plasma cells was determined as described by Lokhorst et al.24
Experimental Parameters
| Patient and Sample Characteristics . | Growth in SCID-hu Hosts . | ||||||||||||
|---|---|---|---|---|---|---|---|---|---|---|---|---|---|
| Patient . | Stage* . | Prior Rx . | M Isotype . | Sample . | (%) PC† . | PC L.I.‡ . | % CD19 . | Cont.1-153 . | Cells (×106)1-155 . | PC1-154 . | Cells (×106)1-155 . | PC- Depleted# . | Cells (×106)1-155 . |
| 1 | III A | Y | IgG κ | BM | 78 | 2.8 | ND | Y | 3 | Y | 3.2 | ND | — |
| 2 | III A | N | IgA κ | BM | 40 | 1.2 | ND | Y | 3 | Y | 2.7 | N | 0.8 |
| 3 | III A | Y | IgG κ | BM | 26 | 2.4 | ND | Y | 3 | N | 0.7 | ND | — |
| 4 | III A | Y | IgA κ | BM | 35 | ND | ND | Y | 2 | Y | 1 | ND | — |
| 5 | III A | Y | κ light chain | BM | 75 | ND | ND | Y | 5 | Y | 2 | N | 0.5 |
| 6 | III A | N | Nonsecretor | BM | 38 | 3.2 | ND | Y | 5 | Y | 3 | N | 3 |
| 7 | III A | N | IgG λ | BM | 50 | 0.2 | ND | Y | 4 | Y | 2.6 | N | 2.7 |
| 8 | III-B | N | IgG κ | BM | 64 | 0.6 | ND | Y | 4 | Y | 2.8 | N | 3.5 |
| 9 | III B | Y | λ light chain | BM | 48 | 0 | ND | Y | 5 | Y | 2 | N | 2 |
| PB | 7.5 | ND | 4 | Y | 10 | ND | — | N | 14 | ||||
| 10 | III A | N | IgG κ | BM | 11 | 0.4 | ND | Y | 5 | ND | — | ND | — |
| PB | 0.1 | ND | 10 | Y | 10 | ND | — | N | 5 | ||||
| 11 | III A | Y | IgG κ | BM | 11 | ND | ND | Y | 10 | ND | — | ND | — |
| PB | 0 | — | 9 | N | 10 | — | — | — | — | ||||
| 12 | I A | N | IgG κ | BM | 30 | ND | ND | Y | 5 | ND | — | ND | — |
| PB | 0.4 | ND | 0 | Y | 10 | ND | — | ND | — | ||||
| 13 | III | N | IgG κ | BM | 48 | 0.6 | ND | ND | — | ND | — | ND | — |
| PB | 14 | ND | 18 | Y | 2 | ND | — | N | 1.5 | ||||
| Patient and Sample Characteristics . | Growth in SCID-hu Hosts . | ||||||||||||
|---|---|---|---|---|---|---|---|---|---|---|---|---|---|
| Patient . | Stage* . | Prior Rx . | M Isotype . | Sample . | (%) PC† . | PC L.I.‡ . | % CD19 . | Cont.1-153 . | Cells (×106)1-155 . | PC1-154 . | Cells (×106)1-155 . | PC- Depleted# . | Cells (×106)1-155 . |
| 1 | III A | Y | IgG κ | BM | 78 | 2.8 | ND | Y | 3 | Y | 3.2 | ND | — |
| 2 | III A | N | IgA κ | BM | 40 | 1.2 | ND | Y | 3 | Y | 2.7 | N | 0.8 |
| 3 | III A | Y | IgG κ | BM | 26 | 2.4 | ND | Y | 3 | N | 0.7 | ND | — |
| 4 | III A | Y | IgA κ | BM | 35 | ND | ND | Y | 2 | Y | 1 | ND | — |
| 5 | III A | Y | κ light chain | BM | 75 | ND | ND | Y | 5 | Y | 2 | N | 0.5 |
| 6 | III A | N | Nonsecretor | BM | 38 | 3.2 | ND | Y | 5 | Y | 3 | N | 3 |
| 7 | III A | N | IgG λ | BM | 50 | 0.2 | ND | Y | 4 | Y | 2.6 | N | 2.7 |
| 8 | III-B | N | IgG κ | BM | 64 | 0.6 | ND | Y | 4 | Y | 2.8 | N | 3.5 |
| 9 | III B | Y | λ light chain | BM | 48 | 0 | ND | Y | 5 | Y | 2 | N | 2 |
| PB | 7.5 | ND | 4 | Y | 10 | ND | — | N | 14 | ||||
| 10 | III A | N | IgG κ | BM | 11 | 0.4 | ND | Y | 5 | ND | — | ND | — |
| PB | 0.1 | ND | 10 | Y | 10 | ND | — | N | 5 | ||||
| 11 | III A | Y | IgG κ | BM | 11 | ND | ND | Y | 10 | ND | — | ND | — |
| PB | 0 | — | 9 | N | 10 | — | — | — | — | ||||
| 12 | I A | N | IgG κ | BM | 30 | ND | ND | Y | 5 | ND | — | ND | — |
| PB | 0.4 | ND | 0 | Y | 10 | ND | — | ND | — | ||||
| 13 | III | N | IgG κ | BM | 48 | 0.6 | ND | ND | — | ND | — | ND | — |
| PB | 14 | ND | 18 | Y | 2 | ND | — | N | 1.5 | ||||
Abbreviations: ND, experiment not done; Y, SCID-hu hosts developed myeloma; N, hosts did not develop myeloma.
Stage according to the Durie Salmon staging.
Percent plasma cells in sample, determined by CD38/CD45 flow cytometry.
BudR labeling index of light chain clg restricted plasma cells.
Unseparated BM or PB cells inoculated into SCID-hu hosts as controls for myeloma development.
Total number of cells inoculated.
SCID-hu hosts injected with purified myeloma plasma cells.
#SCID-hu hosts injected with PC-depleted cells.
Sorting parameters and purity analysis of sorted plasma cells and PC-depleted cells from patient no. 8. Sort windows were set to include CD38++CD45− plasma cells (PC window) and to exclude CD38++CD45− and CD45+ plasma cells (PC-depleted window) (A). Sorted cells were reanalyzed by flow cytometry for purity. The PC fraction contained 99.4% CD38++CD45− plasma cells (B) and the PC-depleted fraction contained 98.5% cells that fell within the parameters of the PC-depleted sort window and 1.2% cells that fell within the PC window.
Sorting parameters and purity analysis of sorted plasma cells and PC-depleted cells from patient no. 8. Sort windows were set to include CD38++CD45− plasma cells (PC window) and to exclude CD38++CD45− and CD45+ plasma cells (PC-depleted window) (A). Sorted cells were reanalyzed by flow cytometry for purity. The PC fraction contained 99.4% CD38++CD45− plasma cells (B) and the PC-depleted fraction contained 98.5% cells that fell within the parameters of the PC-depleted sort window and 1.2% cells that fell within the PC window.
SCID-hu hosts.
CB.17/ICr-SCID mice were obtained from Harlan Sprague Dawley (Indianapolis, IN) and were housed and monitored in our animal facility. The Institutional Animal Care and Use Committee had approved all experimental procedures and protocols. SCID-hu mice were generated as reported.20 A total of 25 to 50 μL of phosphate-buffered saline (PBS) containing 0.7 to 3.2 × 106 purified myeloma plasma cells was injected directly into the human bone in the SCID-hu hosts. Other hosts were injected with unsorted bone marrow cells as controls or with plasma cell-depleted bone marrow cells. In some experiments, blood mononuclear cells (MNC) or plasma cell-depleted blood cells were used. In 2 experiments (patients no. 6 and 9, Table 1), cells recovered from hosts injected with purified myeloma plasma cells were injected into secondary hosts, and in 1 case (patient no. 9), cells recovered from the secondary host were injected into 4 tertiary hosts. In all experiments, increase in the levels of circulating monotypic human Ig (hIg) of the M protein isotype was used as an indicator of myeloma cell growth.
Determination of human Ig levels.
The levels of human IgG, IgA, and κ and λ light chains were determined by enzyme-linked immunosorbent assay (ELISA) as described.21 Briefly, plates were coated with 50 μL/well of primary antihuman κ and λ (5 μg/mL) and antihuman IgA and IgG (10 μg/mL) and incubated overnight at 4°C. Antibodies were purchased from The Binding Site (San Diego, CA). The plates were washed 3 times in PBS containing 0.5% (vol/vol) of Tween 20, then once with blocking buffer (4% bovine serum albumin [BSA] in PBS). A 50-μL sample diluted in PBS containing 1% BSA was added, and the plates were left at room temperature for 2 hours. After washing 3 times with PBS/Tween, 50 μL biotinylated antibody (affinity-purified antihuman κ and λ light chains at 0.5 μg/mL, antihuman IgA, and IgG at 0.2 μg/mL) were added to each well for 1 hour. The plates were then washed and 50 μL streptavidin-horseradish peroxidase was added to each well and allowed to bind for 1 hour. After a final wash, OPD solution (Dako, Carpineteria, CA) containing 3% H2O2 was added. Absorbance at 450 nm was determined on an Auto-Reader II ELISA reader (Ortho Diagnostic Systems, Raritan, NJ).
Methods of analysis.
Tissues and organs recovered from SCID-hu mice were processed as reported.21 Myeloma cells were identified morphologically, by immunohistochemical staining for cytoplasmic Ig (cIg; Dako immunoperoxidase kit), and their clonality was determined by in situ hybridization with patient-specific probes (ASO-ISH). Changes in bone remodeling were identified by x-radiography and increased osteoclast activity was demonstrated by histochemical staining for tartarate-resistant acid phosphatase (TRAP; Sigma, St Louis, MO). Immunohistochemical staining with a monoclonal antibody to CD34 (Cell Marque, Austin, TX) was used to demonstrate neovascularization by human vascular endothelial cells. Monoclonal antibody to human vitronectin receptors (Biosource International, Camarillo, CA) was used to demonstrate the human origin of osteoclasts in the myeloma-bearing human bones.
In situ hybridization.
Clonality of the tumor cells grown in SCID mice was demonstrated by in situ hybridization using an adaptation of published methods,25,26 as reported.21 26 Briefly, antisense oligonucleotide sequences (24 to 32 bp) complementary to CDR III regions of the myeloma clone of each patient were biotinylated during synthesis (Life Technologies, Rockville, MD). Tissue sections were dewaxed in xylene, defatted in chloroform, and then rehydrated. The section were treated with proteinase K (10 μg/mL in Tris-HCl buffer at 37°C for 1 hour). Hybridization mixture containing 50% formamide, 10% dextran, 4× SSC (SSC is 150 mmol/L NaCl, 15 mmol/L trisodium citrate, pH 7), 25 mg/mL Herring sperm DNA, and biotinylated probe (1 to 2 μg/mL) were applied to each section. The sections were covered with Parafilm and incubated overnight in a humidified chamber at 37°C. After hybridization, the slides were washed twice with 1× SSC at room temperature and twice with 1× SSC at 37°C to 42°C (depending on the size of the probe). Signals were visualized using an in situ hybridization kit (Dako). Specificity was determined by using irrelevant patient probes and sections from different patients.
Screening for Epstein-Barr virus (EBV).
Myeloma cells recovered from SCID-hu mice were analyzed for the presence of EBV sequences by PCR.27 All samples were negative.
RESULTS
Purified myeloma plasma cells from 9 patients with myeloma were injected directly into the human bones of SCID-hu hosts. Engraftment and growth of the myeloma cells was followed by the appearance of and increase in the concentrations of the monotypic human Igs in the murine sera. Purified plasma cells from 8 of the patients grew in the hosts. Myeloma growth was detected as early as 3 weeks after the injection of cells and was associated with the typical myeloma manifestations such as severe bone resorption (Table 1). As we have reported previously for SCID-hu hosts injected with myeloma bone marrow cells, myeloma growth was restricted to the human bone, and no other human cells were detected in the blood or other tissues of the hosts.21Myeloma cells recovered from the SCID-hu hosts and in histological sections of decalcified bones were of the same clone as the patients’ myeloma cells as shown by ASO-PCR or ASO-in situ hybridization analyses. All myeloma cells in the SCID-hu hosts expressed cytoplasmic Ig of the M protein isotype; no evidence of isotypic variance was seen. In all cases, growth of myeloma was associated with the expected manifestations: severe bone resorption (Fig 2) resulting from increased activity of osteoclasts and active neoangiogenesis resulting from stimulation of vascular endothelial cells, as we have reported for SCID-hu hosts inoculated with unseparated myeloma bone marrow.21 The osteoclasts and vascular endothelial cells in the myelomatous human bones were human, as attested to by their reactivity with murine monoclonal antibodies to human Vitronectin receptor and to human CD34, respectively (data not shown). Both antibodies reacted only with human cells in the human bones and did not react with murine cells.
Growth of purified myeloma plasma cells (PC) from patient no. 1 in a SCID-hu host. SCID-hu host was inoculated with sorted PC. (A) Human Ig concentrations. (B) Dot plot of CD38/CD45 flow cytometry profile of the cells. The sort window used to purify plasma cells is shown. (C and D) X-radiograms showing severe resorption of the myelomatous implanted bone (C) compared with the nonmyelomatous bone of the control host (D), implanted at the same time as (C).
Growth of purified myeloma plasma cells (PC) from patient no. 1 in a SCID-hu host. SCID-hu host was inoculated with sorted PC. (A) Human Ig concentrations. (B) Dot plot of CD38/CD45 flow cytometry profile of the cells. The sort window used to purify plasma cells is shown. (C and D) X-radiograms showing severe resorption of the myelomatous implanted bone (C) compared with the nonmyelomatous bone of the control host (D), implanted at the same time as (C).
In the experiments in which cells recovered from the hosts were transferred to secondary (2 experiments) and tertiary hosts (1 experiment), all hosts developed myeloma with the typical manifestations. Within the experimental conditions and with the limitation of the small sample size, development of myeloma and the time to initial detection of hIg did not appear to correlate with the number of plasma cells inoculated. In contrast to hosts injected with purified myeloma plasma cells, hosts injected with plasma cell-depleted bone marrow cells from 6 of these patients showed no evidence of myeloma cell growth up to 60 weeks after inoculation (Fig 3 and Table 1).
Human Ig levels (A through C ) and histology of decalcified human bone sections ( D through F ) from SCID-hu hosts inoculated with bone marrow cells ( A and D ), purified plasma cells ( B and E ), and PC-depleted bone marrow cells ( C and F ) from patient no. 2. Inserts demonstrate CD38/CD45 fluorescent profiles and sort windows of cells used for each host.
Human Ig levels (A through C ) and histology of decalcified human bone sections ( D through F ) from SCID-hu hosts inoculated with bone marrow cells ( A and D ), purified plasma cells ( B and E ), and PC-depleted bone marrow cells ( C and F ) from patient no. 2. Inserts demonstrate CD38/CD45 fluorescent profiles and sort windows of cells used for each host.
These results indicate that CD38++CD45−myeloma plasma cells are capable of sustained proliferation and that no other cells in the bone marrow aspirates from patients with myeloma are required to produce myeloma in the SCID-hu hosts. To investigate further whether other cells, specifically circulating B lymphocytes, are able to produce myeloma in the SCID-hu hosts, we injected light-density blood cells from 5 patients (patients no. 9 through 13, Table 1) into SCID-hu hosts. Bone marrow cells from all 4 patients produced myeloma in SCID-hu hosts. Three blood specimens contained myeloma plasma cells. These specimens produced myeloma in the hosts. The blood from 1 patient (patient no. 11, Table 1) did not contain plasma cells and did not produce myeloma in the SCID-hu host. In 2 experiments, blood cells depleted of plasma cells were also inoculated into SCID-hu hosts. In both cases, the hosts did not develop myeloma (Fig 4). Interestingly, although the blood samples contained few myeloma cells compared with the bone marrow samples from the same patients, initial detection of myeloma growth occurred earlier in hosts inoculated with blood cells than in those inoculated with bone marrow cells. This comparison was based on the time required for hosts inoculated with blood and bone marrow cells to reach a landmark hIg level. The hIg levels used for this comparison were the first reached by both hosts in each experiment (except for the blood of patient no. 11, which did not grow at all). Hosts that developed myeloma from blood cells showed the same manifestations as those that were inoculated with bone marrow cells (eg, Fig 4).
Growth of myeloma blood cells from patient no. 10 in SCID-hu host. SCID-hu host was inoculated with blood cells (containing 0.1% plasma cells) and with PC-depleted blood cells. (A) Human Ig levels. (•) Blood cells; (○) PC-depleted blood cells; (▪) host inoculated with bone marrow cells containing 11% myeloma plasma cells. (B) Flow cytometry dot plot of CD38CD45 profile of the blood cells. The sort window excluding CD45− and CD45+plasma cells is shown. (C and D) X-radiograms of host injected with blood cells (C) and with PC-depleted blood cells (D). Note severe decalcification of myelomatous human bone in (C).
Growth of myeloma blood cells from patient no. 10 in SCID-hu host. SCID-hu host was inoculated with blood cells (containing 0.1% plasma cells) and with PC-depleted blood cells. (A) Human Ig levels. (•) Blood cells; (○) PC-depleted blood cells; (▪) host inoculated with bone marrow cells containing 11% myeloma plasma cells. (B) Flow cytometry dot plot of CD38CD45 profile of the blood cells. The sort window excluding CD45− and CD45+plasma cells is shown. (C and D) X-radiograms of host injected with blood cells (C) and with PC-depleted blood cells (D). Note severe decalcification of myelomatous human bone in (C).
In some experiments, mice were implanted contralaterally with 2 human bones each. Only 1 bone was inoculated with myeloma blood or bone marrow cells. In all hosts, although no human hematopoietic cells were detectable in any of the murine organs by flow cytometry, the contralateral second bone showed radiological evidence of resorption and massive infiltration of clonal myeloma cells by histological examination. These results indicate that tumor cells from both the blood and bone marrow disseminated to remote sites, and that although tumor cells disseminate via the murine host system, they require the human microenvironment for growth.
DISCUSSION
The phenotypic heterogeneity of clonal cells in myeloma, combined with the low apparent proliferative activity of the recognizable myeloma plasma cells, prompted the search for a proliferative, preplasmacytic cell compartment with self-renewal capacity (stem cell). However, as the data presented above clearly demonstrate, given a supportive environment, the myeloma plasma cells, hitherto considered nonproliferative, indeed are proliferative, and as our experiments of sequential transfers suggest are capable of inexhaustible proliferation. These cells can populate a nonmyelomatous human bone, produce myeloma and its manifestations in the SCID-hu host, and disseminate to remote sites. This proliferative potential of myeloma plasma cells is not restricted to patients with advanced or terminal disease, as purified myeloma cells from newly diagnosed patients grew in the hosts equally well.
Myeloma cells from both blood and bone marrow traveled through the host circulation to the secondary bone, but grow exclusively in the human bones, underscoring their dependence on the bone marrow stroma. The fact that purified plasma cells grew equally well to unseparated bone marrow cells indicates that the nonmyelomatous bone marrow stroma and accessory cells in the human bones of the SCID-hu hosts can support sustained growth of myeloma cells.
Of particular interest are the data demonstrating that although fewer in numbers, the growth of myeloma plasma cells in the blood of patients in the SCID-hu hosts was detected earlier than those in the bone marrow. This may suggest that circulating myeloma cells represent a subgroup of the bone marrow myeloma plasma cells with a higher growth potential. This notion is further supported by our observation that the residual myeloma cells in the PC-depleted bone marrow samples (eg, Fig 1) consistently failed to grow in the hosts. Such property of the circulating plasma cells would be compatible with the adverse prognostic significance of their proportion in the circulation.28
Our results clearly demonstrate that nonplasmacytic cells in the bone marrow are not required for purified plasma cells to produce myeloma in SCID-hu hosts. While our results suggest that preplasmacytic cells in the blood and bone marrow from myeloma patients cannot produce myeloma in SCID-hu hosts, one cannot draw conclusions as to their role in maintaining the disease process. It is possible that the SCID-hu host does not provide a supportive environment for the preplasmacytic cells in plasma cell-depleted bone marrow or blood specimens to produce myeloma. Although our experiments of sequential transfer suggest that the myeloma plasma cells are capable of inexhaustible proliferation, this point needs to be further investigated.
ACKNOWLEDGMENT
The authors thank Cherie Johnson, Susan Mahaffey, and Jeff Woodliff for their skillful technical assistance. We thank Dr Bart Barlogie and the staff of the Myeloma and Transplantation Research Center for their interest in and support of this work.
Supported in part by Grant No. CA-55819 from the National Cancer Institute.
The publication costs of this article were defrayed in part by page charge payment. This article must therefore be hereby marked “advertisement” in accordance with 18 U.S.C. section 1734 solely to indicate this fact.
REFERENCES
Author notes
Address reprint requests to Joshua Epstein, DSc, MTRC, UAMS, 4301 W Markham, Slot #776, Little Rock, AR 72205; e-mail:jepstein@life.uams.edu.

This feature is available to Subscribers Only
Sign In or Create an Account Close Modal